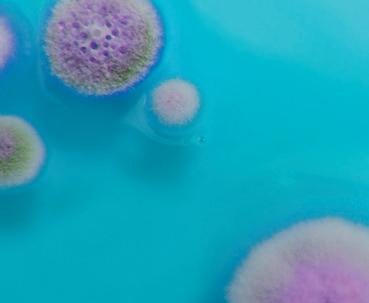

VOGT HAMMER


Højkvalitets tryklufthammer

SPARER TID
OG SKÅNER KROPPEN MOD
ARBEJDSRELATEREDE SKADER
HURTIG EFFEKTIV PÅLIDELIG






Højkvalitets tryklufthammer

SPARER TID
OG SKÅNER KROPPEN MOD
ARBEJDSRELATEREDE SKADER
HURTIG EFFEKTIV PÅLIDELIG




Aldrig har det været så nemt og hurtigt at fjerne stort set alle slags overflade-belægninger i forbindelse med vand og fugtskader m.m.

Traditionelle værktøjer som slaghamre og mejselhamre er tunge og belaster kroppen gennem dårlig arbejdsstilling og arbejdsbevægelser. Endvidere er disse værktøjer uegnede til større opgaver, hvor tid og effektivitet er afgørende for din konkurrenceevne og fortjeneste.


VOGT hammeren er simpelthen et genialt tysk højkvalitets trykluftsværktøj, som sætter en ny standard gennem optimal arbejdsstilling og dine opgaver løses nu med garanti 2-4 gange hurtigere end med alle andre værktøjer, du nogensinde har haft i dine hænder.
Du kan med en VOGT hammer i dit arsenal af udstyr arbejde væsentligt hurtigere og mere effektivt og gøre dit arbejde til en sand fornøjelse.
NAC giver fuld tilfredshedsgaranti på dette unikke værktøj.
VOGT HAMMER – I EN KLASSE FOR SIG SELV
Tryklufthamre har eksisteret i lang tid, alligevel er VOGT Hamrene anderledes. Den lette, lanseformede konstruktion giver dig ideelle arbejdsbetingelser.
Den praktiske robuste opbygning, overlegen materialekvalitet, håndværksmæssig udførelse og lang levetid på værktøjer gør VOGT hammeren velegnet til mange krævende opgaver. Et kæmpe udvalg af værktøjer og muligheden for nemt at skifte mellem forskellige hammerstørrelser åbner en unik vifte af anvendelsesmuligheder. Derfor er Vogt hammeren et meget populært produkt blandt håndværkere i mange forskellige brancher herunder også skadeservicebranchen.
· Afskrælning og skæring af limede gulvbelægninger.

· Fjernelse af tykke lag maling, spartelmasse, skumbagsider og lim.
· Afskrabning af bitumenbaner og gummibelægninger.
· Opstemning af parket limet med elastisk parketlim.

· Fjernelse af keramiske gulv- og vægfliser.
· Opbrydning af cement- og gipsbaserede tyndpudslag.
· Afrensning af grater og toppe på nystøbt beton.


· Fjern alle slags overfladebelægninger 2-4 gange hurtigere end med andre værktøjer.
· Let håndtering pga. lav vægt og udformning.
· Forskellige skaftlængder til opgaver på gulv og væg.
· Ergonomi i top - Optimal arbejdsstilling - Skåner kroppen.
· Opgaver hurtigere udført = større fortjeneste.
· Vibrationsdæmpet.
· Stort værktøjssortiment.

· Hurtigt og nemt værktøjsskift.
· Beskedent luftforbrug - kan drives med 230 V kompressor.
www.nac-europe.com

VOGT HAMMER, MADE IN GERMANY!



Skadesaneringsbranchens power-værktøj, som fjerner alle belægninger på rekordtid, og gør hårdt arbejde til en ren leg.
VOGT hammer er et unikt trykluftværktøj som markant øger din effektivitet, din konkurrenceevne, og som sparer dig for en masse sved, ømme arme og rygproblemer, og som kan anvendes til et utal af små såvel som store opgaver.
Ejer du endnu ikke en VOGT hammer? Så har du nu chancen for at gøre årets bedste værktøjs-investering, og der er naturligvis 100% tilfredshedsgaranti!
NAC EUROPE PRÆSENTERER ET GENIALT VÆRKTØJ, SOM MED
GARANTI BLIVER ET AF DINE FORETRUKNE REDSKABER!
I over 20 år har VOGT hammeren været et uundværligt værktøj i skadeservicebranchen i Tyskland, Østrig og Schweiz og mange andre steder i verden.
ALSIDIGHED OG EFFEKTIVITET – DU FJERNER ALLE BELÆGNINGER UDEN BESVÆR.
VOGT hammeren er et ekstremt alsidigt værktøj, som problemfrit og super hurtigt fjerner de belægninger som ofte fjernes i forbindelse med skadeservicearbejde som f.eks. forskellige gulvbelægninger: klinker, fliser, træ, terrazzo, linoleum, vinyl, kork eller gulvtæpper. Men VOGT hammeren fjerner meget mere end det - puds, vægfliser, epoxy-harpiks, spartelmasse, fliseklæb, mørtelog betonrester, isolering, tagpap, tykke malingslag, tapet, hessian – ja stort set alle belægninger som du kan risikere at skulle fjerne i forbindelse med skaden.
DU HAR ALLEREDE EN MEJSELHAMMER!
Jeg har allerede en elektrisk mejselhammer, er den ikke lige så god? Nej, mejselhamre kan ikke sammenlignes med en VOGT hammer. Mejselhamre er primært til fliser og puds, en VOGT hammer er et universelt tryklufts baseret værktøj, som fjerner belægninger hurtigere, lettere og mere effektivt end du nogensinde har oplevet, og leveres med forskellige værktøjer som gør fjernelsen af alle slags belægninger til en ren leg.
ERGONOMI I SÆRKLASSE
VOGT hammerens stav-design, gør at din arbejdsstilling er optimal under hele dit arbejde med hammeren – du beskytter dermed din krop mod arbejdsrelaterede skader.

KRÆVER KUN EN LILLE OG EFFEKTIV KOMPRESSOR
De mindre VOGT hamre op til 90 cm kræver kun 190 liter luft i minuttet og de lange versioner 255 liter i minuttet. Altså har du sikkert allerede en lille kompakt kompressor, som kan klare dette.

DIN KONKURRENCE-EVNE STIGER MARKANT – DET VIL ENHVER EJER AF EN VOGT HAMMER MED GARANTI SKRIVE UNDER PÅ!
At eje en VOGT hammer betyder, at du med ro i sindet kan afgive tilbud på store og/eller udfordrende opgaver hvor genstridige belægninger skal fjernes, fordi du ved, at du har en VOGT hammer til at klare jobbet for dig.
EN VOGT HAMMER ER HURTIGT TILBAGEBETALT
En investering i en VOGT hammer er som regel tilbagebetalt efter få jobs, p.g.a. dens suveræne ydeevne.

HVILKEN VOGT HAMMER SKAL JEG KØBE?
Vi anbefaler universal modellen VH30-90 S XL / XL-SÆT. Dette er vores populære allrounder, som er 90 cm lang og kun vejer 4,3 kg uden værktøj. Med en VH-30-90 hammer kan du lave gulve og vægge, samt løfte hammeren så du også kan nå loftet.
Hvis du overvejende arbejder med gulve, så er slagkraft og vægt ved seje materialer en fordel. Med en længde på 130 cm er du sikret en oprejst og ergonomisk korrekt arbejdsstilling. Vi anbefaler derfor VOGT hammer VH60-130 18B-XL / XL-SÆT som er gulvbranchens foretrukne VOGT hammer.
ER DER NOGEN RISIKO FORBUNDET MED MIT KØB
AF EN VOGT HAMMER?
Slet ikke, skulle VOGT hammeren ikke leve op til dine forventninger kan du frit returnere den efter 1 måned, og du får dine penge retur. Vi tror dog næppe, at det bliver aktuelt!


ARBEJDER DU OGSÅ MED INDUSTRISERVICE?

Tilbyder dit skadeservicefirma også industriservice, så klarer en VOGT hammer mange opgaver indenfor industrien. VOGT hammeren er et ekstremt populært redskab til at fjerne belægninger hos produktionsvirksomheder som arbejder med beton, cement, papirmasse, maling, byggematerialer, klæbrige/pastøse produkter, gødning, slam, kul m.v. VOGT hammeren fjerner belægninger fra siloer, transportsnegle, transportskruer, blandekar, tragte, ovne og alle andre steder hvor råmaterialer eller færdigvarer kan være svære at fjerne fra produktionsudstyr o. lign.
www.nac-europe.com

SKADESERVICE, MALERE, MURERE OG FLISELÆGGERE

Fås i følgende længder til samme pris:
70 cm - 4,0 kg
90 cm - 4,3 kg
110 cm - 4,6 kg
130 cm - 4,9 kg
VOGT hammer VH30 – den lette Den lille VH30 VOGT hammer er kun halvt så tung som tilsvarende elektriske hamre, hvilket forenkler arbejde over hovedhøjde. Allerede med VH30-70 når man fra lofts- til gulvhøjde uden brug af stillads og uden at skulle bukke sig. Den højere slagfrekvens på VH30 er ideel til sprøde materialer: epoxy-harpiks, puds, spartelmasse, tynde fliser, fliseklæb, mørtel- og betonrester. Det lille slagværk bruger kun 190 liter i minuttet.
VH30-90S (14 mm)
Luftforbrug Længde Vægt 190 l/min / 3-6 bar 90 cm 4,3 kg
VH30 - 70 cm
VH30-70S
VH30-70S 16.435,00
VH30-90S
VH30 - 110 cm
VH30 - 70 cm VH30 - 90 cm VH30 - 130 cm
VH30 - 110 cm
VH30-110S
VH30 - 90 cm VH30 - 130 cm
VH30-130S
Værktøj
1 Delta-P kniv M410P
1 bredmejsel M340
1 skrabejernsholder M5000
1 skrabejern B120S
Tilbehør
1 adapter ¾" til standardtilslutning Z200
1 præcisionsoliedosering til slange Z300
10 mtr. trykluftslange komplet med tilslutning
0,1 ltr. VOGT specialolie
Ringnøgle 15/19
VOGT Hammer – Højkvalitets trykluftsværktøj
Beskyttelsesudstyr
Arbejdshandsker
Beskyttelsesbriller
Ørepropper
Metal-transportkuffert med betjeningsvejledning
SKADESERVICE, MALERE, MURERE
VOGT hammer VH30 – den lette Den lille VH30 VOGT hammer er kun halvt så tung som tilsvarende elektriske hamre, hvilket forenkler arbejde over hovedhøjde. Allerede med VH30-70 når man fra lofts- til gulvhøjde uden brug af stillads og uden at skulle bukke sig. Den højere slagfrekvens på VH30 er ideel til sprøde materialer: epoxy-harpiks, puds, spartelmasse, tynde fliser, fliseklæb, mørtel- og betonrester. Det lille slagværk bruger kun 190 liter i minuttet.

Værktøj
1 Delta-P kniv M410P
1 bredmejsel M340
1 fladmejsel M200
1 skrabejernsholder M5000
1 skrabejern B100S
1 skrabejern B120S
1 skrabejern B160S
Tilbehør
1 adapter ¾" til standardtilslutning Z200

1 præcisionsoliedosering til slange Z300

10 mtr. trykluftslange komplet med tilslutning
ltr. VOGT specialolie
Beskyttelsesudstyr
www.nac-europe.com

VH30 - 70 cm - XL-sæt
VH30 - 90 cm - XL-sæt
Fås i følgende længder til samme pris: VH30 - 110 cm - XL-sæt


Fås i følgende længder til samme pris:
- 5,9 kg
cm - 6,3 kg
cm - 6,7 kg
VH60 – den stærke VH60 er et nummer større: den mere kraftfulde kolbe er velegnet til seje, kompakte materialer: bitumen, cement, gips og murværk. Selv seje limrester fra parketgulve kan ikke modstå det stærke slagværk. Den stærke 18 mm mejsel betyder, at løfteevnen i forbindelse med underminering eller opbrydning af flade tage er høj.
Værktøj
1 Delta-P kniv M408.18 UP
1 skrabejernsholder M5000.18
1 skrabejern B160S
1 skrabejern B200S
Tilbehør
1 håndtag Z650
1 præcisionsoliedosering til slange Z300
10 mtr. trykluftslange komplet med tilslutning
0,1 ltr. VOGT specialolie
Ringnøgle 15/19
VOGT Hammer – Højkvalitets trykluftsværktøj
Beskyttelsesudstyr
Arbejdshandsker
Beskyttelsesbriller
Ørepropper
Metal-transportkuffert med betjeningsvejledning
SKADESERVICE, MALERE, MURERE OG FLISELÆGGERE


VH60 – den stærke VH60 er et nummer større: den mere kraftfulde kolbe er velegnet til seje, kompakte materialer: bitumen, cement, gips og murværk. Selv seje limrester fra parketgulve kan ikke modstå det stærke slagværk. Den stærke 18 mm mejsel betyder, at løfteevnen i forbindelse med underminering eller opbrydning af flade tage er høj.
Værktøj
1 Delta-P kniv M408.18 UP
2 skrabejernsholder M5000.18
1 skrabejern B120S
1 skrabejern B160S
1 skrabejern B200S
1 Franken specialklinge B120LF
1 parketkile PK90
1 krydsklingeholder m. krydsklinge H100B
Tilbehør
1 håndtag Z650
1 præcisionsoliedosering til slange Z300

10 mtr. trykluftslange komplet med tilslutning
0,1 ltr. VOGT specialolie
1,0 ltr. VOGT specialolie

Ringnøgle 15/19
Beskyttelsesudstyr
Arbejdshandsker
Beskyttelsesbriller Ørepropper
Metal-transportkuffert med betjeningsvejledning
www.nac-europe.com

VOGT hammer VH30-70 (14 mm)
VOGT hammer VH30-90 (14 mm)
VOGT hammer VH60-130.18 (18 mm)





Skrabejernsholder
L x B = 300 x 100 / vinklet, med fastgøringssæt 902 011
til 14 mm
til 18 mm
Skraber
Puds på jævnt underlag, belægninger, tyndpuds, sprøjteasbest, limede fliser, limrester, betonrester, vejmarkeringer. B100S L120 x B100 - B120S L120 x B120
Skraber
Rester af bitumen, lim, maling og spartelmasse. PVC-, vinyl-, linoleum- og gummibelægninger. Kork, nålefilt, tæppe. B160S L120 x B160 - B200S L120 x B200
Monteringsskruer
Fastgøringsskruer til skrabejernsholder.
Forstærkningsplade
Lille forstærkningsplade til skrabejernsholder til skrabere op til 120 mm bredde.
Forstærkningsplade
Stor forstærkningsplade til skrabejernsholder til skrabere fra 160 mm bredde.
Delta-P kniv
Vinklet med underslibning, Kalk- og gipspuds, parket, laminat, bitumen, kraftige klinker, naturstensplader, magnesitbundne træulds-, letvægts- og gipskartonplader, lægteværk.
M408UP til 14 mm, L300 x B80
M408.18UP til 18 mm, L300 x B80
M410UP til 14 mm, L300 x B100
M410.18UP til 18 mm, L300 x B100
Spidsmejsel
Beton, klippe, kalksandstensmure.
M100 til 14 mm, L = 260




M100.18 til 18 mm, L = 300

VOGT Hammer – Højkvalitets trykluftsværktøj

Fladmejsel
Beton, klippe, murværk, støbte gulve, klinker på kraftigt underlag, cementpuds.
M200 til 14 mm, L260 x B25 - M200.18 til 18 mm, L300 x B25


Bredmejsel
Hårdnakket puds, murværk, klinker på kraftigt underlag, svømmende gulve.
M340 til 14 mm, L260 x B40 - M340.18 til 18 mm, L300 x B40
Bredmejsel
Cement- og kalkcementpuds.
M360 til 14 mm, L260 x B60 - M360.18 til 18 mm, L300 x B60
Stokhammer



Opkradsning og nedbrydning af kanter af beton, støbte gulve, sandsten og granit, 7 x 7 tænder.
S860H til 14 mm, L60 x B60 - S860.18H til 18 mm, L60 x B60
Gravespade

Universel, hård jordbund (*Reduceret slagkraft ved VH30).
GA140H til 14 mm, L420 x B140 *
GA140.18H til 18 mm, L420 x B140



Fugemejsel
Fugemejsel på ruller. Fjerner smalle fuger, puds og cementsamlinger i en ensartet dybde op til 20 mm.
M605R til 14 mm, L300 x B5 - M607R til 14 mm, L300 x B7

Franken specialklinge Opskæring af elastisk PU-lim under parket og laminat, under facadebelægning og skibsdæk. Jo sejere klæbestoffet er, desto smallere skal klingen være. L200 x B120. Til panelbredde 100 til 150 mm
Parketkile

Med fastgøringssæt 90 20 60, reducerer gnidningsmodstanden på PU-limen. B = 90 mm

Krydsklingeholder m. klinge
Krydsklingeholder til opskæring af bløde belægninger i vilkårlige bredder.
Dobbelt krydsklingeholder med klinger
Dobbelt krydsklingeholder til opskæring af bløde belægninger i baner. Jo hårdere/ kraftigere belægning, desto smallere dobbelt krydsklingeholder. B = 200 mm

Krydsklinge – slebet på begge sider

Løsner og skærer bløde belægninger. Egnet til H100B, B120B, H160B, H200B.

Opsprætningsværktøj
Skærer bløde belægninger og et- eller flerlags tætninger.
Opsprætningsklinge
Skærer bløde belægninger og et- eller flerlags tætninger.
Metal slangetromle


PU-trykluftsslange 10 x 15 mm.
Komplet med tilslutninger og knækbeskyttelse.
L = 20 m
Z100 1.740,00 pr. stk.
PU-trykluftslange
Meget fleksibel slange 9 x 14 mm.

Komplet med tilslutninger.
L = 10 m
Z110



Kaeser Premium Compact

Effektiv 2-cylindret kompressorblok, produceret i Tyskland, med lyddæmpende luftfiltre. Specielt design giver nem håndtering. Ideel til anvendelse sammen med VOGT hammer.
Tekniske data
Luftindtag: 450 l/min
Luftvolumen: 370 l/min.
Leveret luftmængde ved 7 bar: 282 l/min
Tankindhold: 30 l
Energi: 230 V / 16 A / 2,2 kW
Vægt: 68 kg
Adapter
¾" med standardtilslutning
Adapter

¾" med 2 x standardtilslutning

Tryklufttilslutning
Tryklufttilslutning til lastvogn.
Til anvendelse af apparat vha. trykluft fra lastvogn.
Trykregulator




Med manometer-metalbeskyttelse, standardtilslutning, justering fra 0,5 – 10 bar.


Præcisions-ledningssmøreapparat
Vedligeholdelsestilbehør til VH / VTS, smører apparatet og mejslens trykabsorbering.
VOGT special-olie

Udskiller ikke harpiks – sørger for konstant slagkraftstyrke.
Z510 0,1 liter
Z500 1 liter

Z550 5 liter
Håndtag
Optimerer kontrollen af apparatet.
Z625 til VH30
Z650 til VH60
www.nac-europe.com